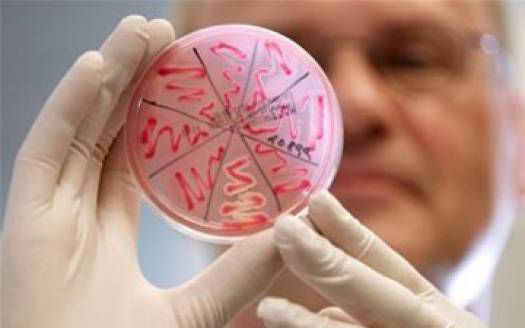
В Ялте высокая заболеваемость детей кишечными инфекциями

На территории Ялты наблюдается высокая заболеваемость кишечными инфекциями среди детей до 17 лет. Об этом сегодня на оперативно-хозяйственном совещании сообщил главный санитарный врач Ялты Виталий Задорожний.
В целом, по его словам, за прошедшую неделю заболеваемость кишечными инфекциями в городе значительно снизилась по сравнению с аналогичным периодом прошлого года. Так на территории Ялты заболело 38 человек, по сравнению с 49 случаями в аналогичный период прошлого года.
Вместе с тем большинство из тех, кто заболел и оказался в инфекционном стационаре Ялты – дети до 17 лет. От общего числа пациентов с кишечной инфекцией дети составляют 77%. Виталий Задорожний призвал не покупать продукты питания на стихийных рынках и обязательно мыть фрукты и овощи перед употреблением.
От общего числа пациентов с кишечной инфекцией примерно половину составляют туристы, приехавшие в Ялту на отдых. При этом главный санитарный врач отметил, что многие заболевшие кишечными инфекциями не обращаются в больницу и пытаются лечиться самостоятельно.
